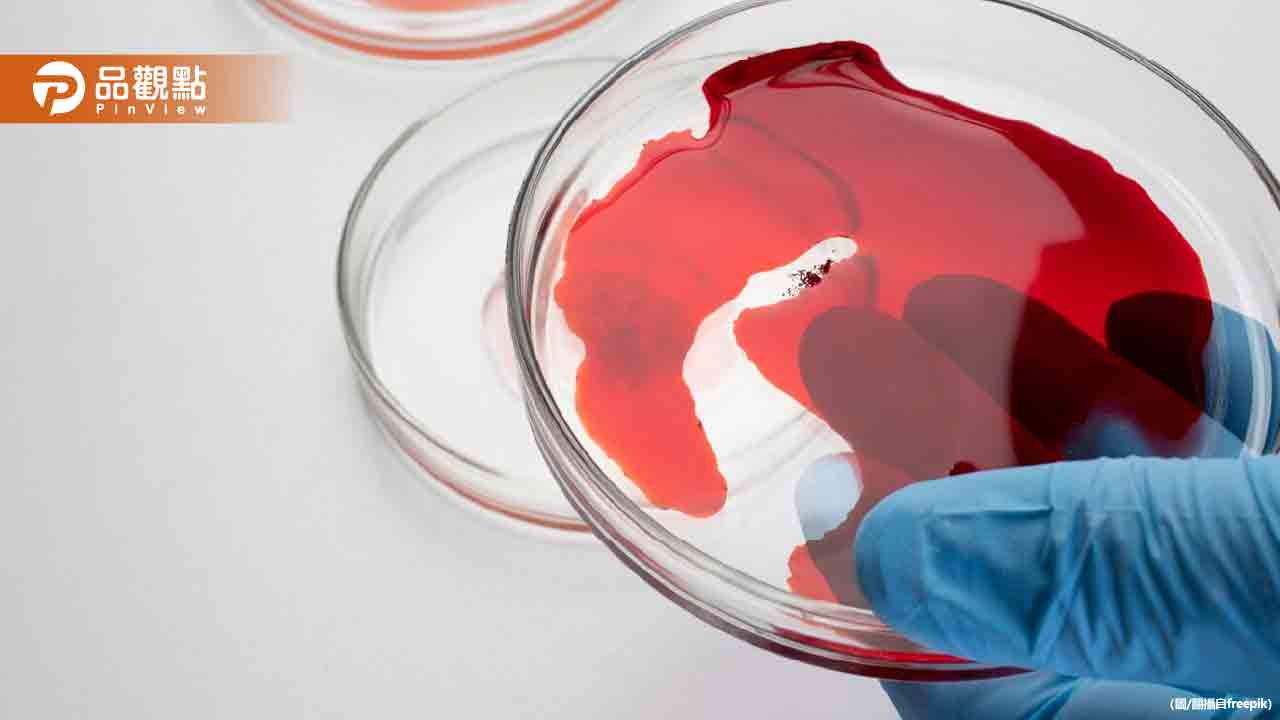
4血型好發疾病!醫:A型易胃癌、AB型注意心血管 4血型好發疾病!醫:A型易胃癌、AB型注意心血管

近期研究發現,血型與某些疾病的發生風險存在關聯。台北榮總遺傳優生科主任張家銘醫師指出,血型實際上是指紅血球表面的糖分子組合,這些糖分子不僅影響輸血相容性,還會影響病原體的黏附能力,進而導致不同血型者面臨不同的健康風險。
張醫師解釋,紅血球表面的糖分子存在於全身,包括腸胃道、呼吸道和血管內壁,影響著身體如何對抗病原體、血液流動和凝血功能,甚至與癌症風險有關。他進一步分析了四種血型的健康風險:
A型血者的紅血球表面帶有A型糖分子,某些細菌如幽門螺旋桿菌特別容易附著,因此罹患胃癌的機率較高。此外,A型血者的免疫系統容易產生較強的發炎反應,可能增加心血管疾病風險。建議A型血者特別注意胃部健康,定期檢查幽門螺旋桿菌感染,並多攝取抗發炎食物如深色蔬菜和Omega-3脂肪酸。
B型血者的紅血球帶有B型糖分子,與B型肝炎病毒關係密切,因此感染B型肝炎的機率較高,也較易發展為慢性肝病或肝癌。建議B型血者特別注意肝臟健康,確認是否已接種B肝疫苗,若已帶有B肝病毒則需定期追蹤肝功能。同時應避免過量飲酒,減少加工食品和高脂肪飲食。
O型血者的紅血球表面沒有A或B型糖分子,某些病菌較難找到附著點,但也面臨其他健康挑戰。O型血者的凝血功能較弱,出血性疾病風險較高。此外,O型血者胃酸分泌較多,容易引發胃潰瘍。建議減少刺激性食物攝取,出現胃痛或消化不良時及早就醫。
AB型血者同時帶有A和B型糖分子,可能同時承擔A型和B型血的健康風險。AB型血者的心血管疾病風險高於O型血,免疫系統反應也較為複雜。建議AB型血者同時關注心血管和肝臟健康,保持規律運動、均衡飲食,並定期進行健康檢查。
張醫師強調,血型只是決定健康風險的因素之一,生活習慣才是關鍵。了解自身血型相關的健康弱點後,應針對性地進行預防,保持良好的生活習慣,才能有效降低疾病風險。他呼籲民眾不要過度擔心,血型並不意味著一定會罹患某種疾病,重要的是根據自身情況採取適當的預防措施。
專家建議,無論何種血型,維持健康的生活方式都至關重要。這包括均衡飲食、規律運動、充足睡眠、戒煙限酒等。同時,定期進行健康檢查,及早發現潛在的健康問題,才能真正達到疾病預防的目的。